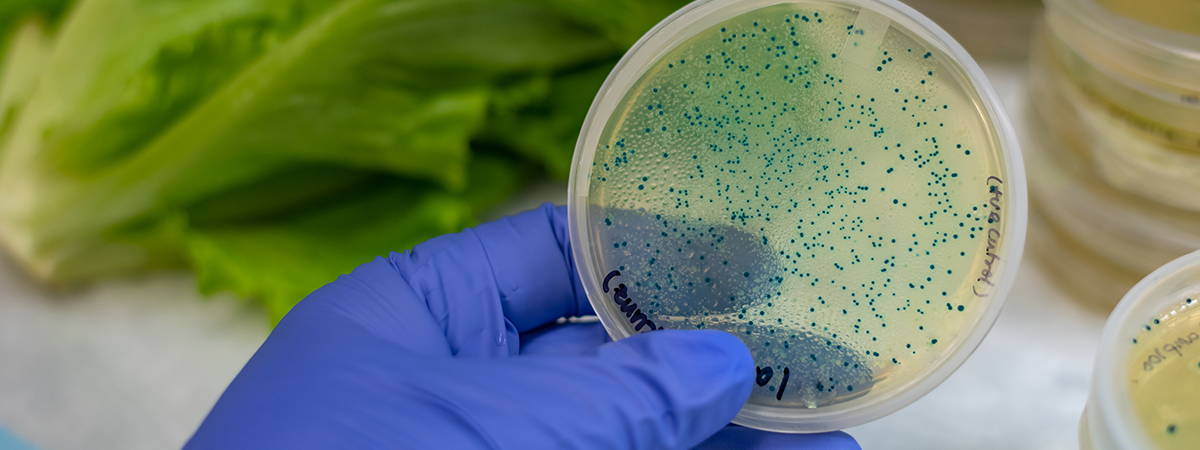

Resource Library


Resource Library
Take advantage of our vast library of complimentary learning materials and stay up to date on the latest in business software and best practices.

HRMS/Payroll Software
Things to Consider when Switching Payroll Providers
Watch this on-demand webinar where we explore best practices when considering a payroll provider switch. We’ll be joined by Marisa Perez, HR Operations Manager at PuzzleHR, the premier HR Service provider, who will share valuable insights to assist you when considering this important decision.
Read more
Sage X3
ERP’s Role in Managing Food Recalls
A food recall is every Food & Beverage processor and distributor’s biggest threat to profitability. But it doesn’t have to spell disaster for your business – as long as your team is prepared. Pairing your needs with the right technology platform will help safeguard daily operations as well as mitigate damages to your reputation and bottom line in the event of a recall.
Read more

Sage 500 ERP
Sage X3
Sage Enterprise Intelligence (SEI) for Sage X3/500 – New Release Overview
Sage Enterprise Intelligence directly links to your Sage 500 / Sage X3 ERP helping you easily transform complex data into meaningful information that has real decision-making power.
Read more

Digital Transformation
HRMS/Payroll Software
Demystifying Digital Enablement in HR
Adoption of digital tools to enable Human Resources professionals has been underway for some time. However, the events of the last 12 months have compelled organizations to accelerate the pace of adoption of digital technology in months instead of years.
Read more

Construction Industry
Sage X3
Sage X3 for the Construction Aggregates Industry
Streamline Operations with End-to-End Process Integration. Sage X3 ERP offers rich & integrated functionality to support core business processes required in the construction aggregates industry – with minimal IT investment and resources. From procurement to warehousing, production, sales, customer service and financial management, Sage X3 better manages your business on a global scale.
Read more

Sage CRM
Accelerator Outlook Integration for Sage CRM
Watch this on-demand webinar where our partners at CRM Together will show how the Accelerator integration tool links your emails directly to Sage CRM, establishing context, filing communications, creating new contacts, opportunities or cases.
Read more

Digital Transformation
Chemical Industry
Digital Transformation in the Chemical Industry
Quality, risk, and regulation remain top priorities as chemical companies face an evolving regulatory environment, increasingly compete on quality, and manage various risks. For years, this process-heavy industry has been fighting declining margins, product commoditization, competition (especially from developing countries), and customers demanding more with less.
Read more

Digital Transformation
HRMS/Payroll Software
Non-Profit Solutions
How HR Technology Helped Goodwill Industries of Dallas Thrive
Join us as we discuss adoption of digital HR technology at Goodwill Industries of Dallas and how it has helped them survive the pandemic. We will be speaking with Mark V. Welsh, Chief Financial Officer for Goodwill Industries of Dallas about the challenges they faced and how they overcame them.
Read more

Sage HRMS
Sage HRMS Best Practices – Payroll Secure Query
Looking for a simpler way to create Sage HRMS Payroll reports? Look no further than Secure Query.
Read more




